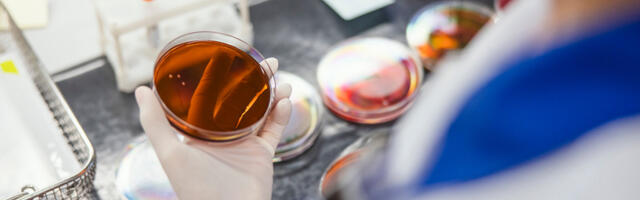
LABRIS teeb igapäevaselt tööd sigade Aafrika katku laborianalüüside usaldusväärsuse tagamiseks

8 koht 30
Riigi Laboriuuringute ja Riskihindamise Keskus (LABRIS) on ainus labor Eestis, kus tehakse sigade Aafrika katku (SAK) analüüse. Alates epideemia algusest 2014. aastal oleme teinud enam kui 100 000 SAKi analüüsi, millest positiivseid on olnud üle 3000. LABRISe direktor Heli Reinet sõnab, et kõik SAKi analüüsid on tehtud akrediteeritud analüüsimeetoditega, mille diagnostiline suutlikkus ja usaldusväärsus on kinnitatud nii ...
Tähtsamad uudised sinu postkastis!
Saadame välja 10 olulisemat Eesti uudist keskpäeva paiku igapäevases uudiskirjas. Vajuta nuppu ja me saadame sulle vaid kõige tähtsamad uudised ja koroonaviiruse infot ja ei saada spämmi.
Pane LIKE Facebook-is ja ära maga maha päeva kõige tähtsamat uudist!
Iga päev ei saa olla täis ainult häid uudiseid ja lihtsaid lahendusi. Mõnikord toob elu meie teele väljakutseid, Vaata lähemalt ›
0 uustulnuk
Mõnikord tundub, et elu seisab paigal. Pingutad, ootad vastuseid ja loodad muutustele, kuid miski ei näi liikuvat. Kolmapäev, Vaata lähemalt ›
0 uustulnuk
Kolmapäev toob kaasa rahulikuma energia, mis soosib keha ja vaimu tasakaalu leidmist. Täna on oluline kuulata oma organismi Vaata lähemalt ›
0 uustulnuk
Kuigi positiivset energiat jagub kõigile, paistavad neli sodiaagimärki täna eriti silma. Universum näib avavat neile uksi, mis on Vaata lähemalt ›
0 uustulnuk
Mõnikord võib üksindus tunduda lõputuna. On perioode, mil tundub, et õige inimene ei jõua kunagi kohale, mõistmist jääb Vaata lähemalt ›
0 uustulnuk
Kolmapäev kannab endas õnne, juhuste ja positiivsete kokkusattumuste energiat. Kuigi lotovõit ei sõltu ainult tähtedest, võivad mõned tähemärgid Vaata lähemalt ›
0 uustulnuk
Kolmapäev toob töö-, raha- ja karjäärivaldkonda praktilist ning edasiviivat energiat. Päev soosib läbimõeldud otsuseid, uute võimaluste märkamist ja Vaata lähemalt ›
0 uustulnuk
Kolmapäev toob paljudele positiivseid võimalusi, kuid kolme tähemärki saadab täna eriti tugev õnne-, edu- ja rõõmuenergia. Universum soosib Vaata lähemalt ›
0 uustulnuk
Eesti tennisist Ingrid Neel ja tema mehhiklannast mängupartner Giuliana Olmos pääsesid Eastbourne'is toimuval WTA tenniseturniiril paarismängu veerandfinaali. Vaata lähemalt ›
0 uustulnuk
Jaanipäev on eestlaste jaoks aeg, kus paljud lähevad oma juurte juurde või veedetakse aega oma lähedastega. Eesti saarte rahvastik kasvab neil päevil mitmekordseks Vaata lähemalt ›
0 uustulnuk
Teisipäeval tähistati jaanilaupäeva. Mitmed vanad traditsioonid on ajas muutunud või kadunud, kuid peamine eesmärk, et inimesed saaksid lõkke ees kokku, on ajas püsima jäänud. Vaata lähemalt ›
0 uustulnuk
Kõrgrõhuala, mis meie ilma kuivana hoidis koondub aina enam Kesk-Euroopa kohale. Samas üle Soome ja Skandinaavia sirutuv madalrõhuvöönd laieneb üle Läänemere Eesti kohale. See tähendab, et hommikuks jõuavad esimesed sajuhood saartele ja mandri põhjaossa. Jaanipäev tuleb seega hoovihmadega. Vaata lähemalt ›
0 uustulnuk
Kolmapäev toob kaasa tasakaaluka ja positiivse energia, mis soosib tarku otsuseid, meeldivaid kohtumisi ning ootamatuid võimalusi. Mõne tähemärgi Vaata lähemalt ›
0 värske
Kolmapäeva energia kutsub kuulama oma sisemist tarkust ja märkama märke, mida elu sulle saadab. Tarot-kaardid viitavad täna sellele, Vaata lähemalt ›
0 värske
Armastuse energia on täna rahulik, siiras ja südamlik. See on päev, mil paljud inimesed tunnevad vajadust olla lähemal Vaata lähemalt ›
0 värske
Kolmapäev toob kaasa rahulikuma ja tasakaalukama energia, mis aitab näha selgemalt nii oma eesmärke kui ka ümbritsevaid olukordi. Vaata lähemalt ›
0 värske
Kes jaanilaupäeval magada ei soovi, võib öö läbi lõkke kõrval jalgpalli maailmameistrivõistluseid nautida, sest menüü on kirev. Vaata lähemalt ›
0 värske
Ronaldo kerkis esimeseks kuuel MM-il skoorinud jalgpalluriks ja ületas veel mitu rekordit Vaata lähemalt ›
0 värske
Varases eas tundub intiimsus lihtne ja automaatne, kuid keskeas see iseeneslikkus sageli kaob. Pärast 40. eluaastat kuhjuvad igapäevakohustused, laste kasvatamine ja karjääripinged. Naiste puhul lisanduvad perimenopausi ja menopausi hormonaalsed muutused (östrogeeni ja testosterooni langus), mis toovad kaasa väsimuse, unetuse, libiido languse ning sageli ka füüsilise ebamugavustunde või kuivuse vahekorra ajal. Vaata lähemalt ›
0 värske
Teisipäeval, 16. juunil kell 14.24 toimus liiklusõnnetus Viljandis Posti tn 28 juures. 37-aastase mehe juhitud sõiduauto Volvo V70 põrkas vasakpööret sooritades kokku kõnniteelt lähenenud jalgratturiga, 13-aastase poisiga. Jalgrattur toimetati haiglasse. Vaata lähemalt ›
0
Kokkuhoidlikult majandavad inimesed võrdlevad regulaarselt elektri-, side- ja kindlustuspakkumisi, kuid pangateenuste kulud jäävad paljudel aastateks tähelepanuta. Coop Panga igapäevapanganduse äriliini juht Moonika Maaring annab nõu, millele pankade pakette ja teenuseid võrreldes tähelepanu pöörata. Pangakonto avatakse sageli juba noorena ning sama panka kasutatakse seejärel aastaid harjumusest. Aja jooksul võivad aga muutuda sinu enda vajadused kui ka ... Vaata lähemalt ›
0
„Kellele ma helistan, kui tahan Euroopaga rääkida?” Kuigi Henry Kissinger eitas, et ta oli seda kunagi öelnud, on see ebamugav küsimus sama terav kui kunagi varem. Euroopa Liidul on alates 2010. aastast olnud dünaamiliselt nimetatud välisteenistus (EEAS). Viimased 18 kuud on endine Eesti peaminister Kaja Kallas täitnud Euroopa välisasjade ja julgeolekupoliitika kõrge esindaja olulist rolli, ... Vaata lähemalt ›
0
Lõunaeestlane jätkab sõjanduse asjatundja Toomas Piirmanni ülevaatega sündmuste kohta Ukraina sõjas. Ukraina 17. juuni 2026: oli nii edenemisi kui taandumisi ja kütuse mured venemaal tõusuteel nagu ka eelarve augu kasv… 1. Kõik sihtmärgiks sobib. 2. Krimmi ja Krasnodari suunal enamus teele läks. 3. Kursk: ühe piiri küla vene pool enda kontrolli alla sai. 4. Harkiv: ... Vaata lähemalt ›
0
Tervise Arengu Instituudi (TAI) avaldatud psühhiaatriateenuse statistikast selgub, et 2025. aastal registreerisid psühhiaatrid ambulatoorsetel vastuvõttudel üle 97 000 psüühika- ja käitumishäire haigusjuhu, mida oli 2% vähem kui 2024. aastal. Vajadus psühhiaatrilise abi järele ei ole vähenenud. Psühhiaatrite koormust aitab leevendada vaimse tervise abi pakkuvate teenuseosutajate arvu kasv. Kliinilised psühholoogid on võrdsustatud tervishoiutöötajatega ja nad saavad abi osutada nii ... Vaata lähemalt ›
0
Täna avaldatud iga-aastase ELi suplusvee aruande kohaselt vastab valdav osa ehk 85% Euroopa suplusvetest rangeimatele kvaliteedistandarditele ning 96% kõigist ELi supluskohtadest täidab kvaliteedi miinimumnõudeid. Eelmise aastaga võrreldes on suplusvee üldine kvaliteet kogu Euroopas püsinud stabiilne. Kõrgeima kvaliteediga suplusvee osakaal on suurim Austrias, Bulgaarias, Küprosel ja Kreekas, kus selliseid supluskohti on kokku 95% või rohkem. Rannikuvee ... Vaata lähemalt ›
0
Sotsiaalmeediasse on pandud video, kuidas G7 tippkohtumisel osalevad riigijuhid räägivad omavahel ja Itaalia peaminister Giorgia Meloni tunnistab järsku, et jättis suitsetamise maha. Teised on imestunud, samas kiidavad seda otsust. Meloni ütles, et tegi seda juba kuu aega tagasi. Euroopa Ülemkogu eesistuja, endine Portugali peaminister Antonio Costa ütleb selle peale, et tema jättis maha 2005. aastal, ... Vaata lähemalt ›
0
Eile teisipäeval 16. juunil avastas Mustvee kordoni Mehikoorma teenistuse radarivaatleja, et Lämmijärvel on kalameeste mõrralipp paigaldatud mitmekümne meetri sügavusele piirirežiimi alasse. Piirivalvurid suundusid sündmuskohale ning vestlesid kahe kaluriga, kes olid mõrralipu oma paadiga sinna viinud. Mehed tunnistasid eksimust ning paadijuhile määrati 200-eurone rahatrahv. Vaata lähemalt ›
0
Petturid on võtnud kasutusele Google’i otsingureklaamid, et suunata inimesi SEB nime all loodud võltsveebilehtedele. Libalehele andmed sisestanud klientide nimel püütakse teha maksetehinguid ning täiendavalt kätte saada kaardiandmeid. „Skeem töötab nii, et inimene otsib Google’is märksõna „SEB” või „SEB internetipank” ning päris kodulehe asemel kuvatakse otsingu tipus mitu sponsoreeritud tulemust, mis viivad petturite lehtedele. Tegemist on ebatavalise ründemustriga, kus petturid ei võta kliendiga ise ühend Vaata lähemalt ›
0
Lätil ja Leedul olid naistest peaministrid, ent see ei kestnud kaua – nii Läti peaminister Evika Siliņa kui Leedu peaminister Inga Ruginienė astusid ametist tagasi. Läti uus peaminister on Andris Kulbergs (Ühendatud nimekiri – Apvienotais saraksts). Ta astus ametisse 28. mail pärast uue parempoolse koalitsiooni moodustamist pärast eelmise peaministri Evika Siliņa tagasiastumist droonikriisi tõttu. Leedul ... Vaata lähemalt ›
0
Populaarsemad allikad
|
|
0% |
|
|
0% |
|
|
0% |
|
|
0% |
|
|
0% |
| Vaata allikaid » | |
Pane LIKE Facebook-is ja ära maga maha päeva kõige tähtsamat uudist!
23.06.2026 21:34
Viimane uuendus: 21:28.
Uudiste reiting uuendatud: 21:21.
Mis on Uudis.net?
Uudis.net näitab populaarsemate uudiste edetabelit erinevatest Eesti uudisteportaalidest.
Meie tööpõhimõttetest loe lähemalt KKK rubriigist.
Keele valik
Српски / srpski Eesti keel (Eesti uudised) Русский язык (новости Эстонии) Українська мова (новини Естонії)